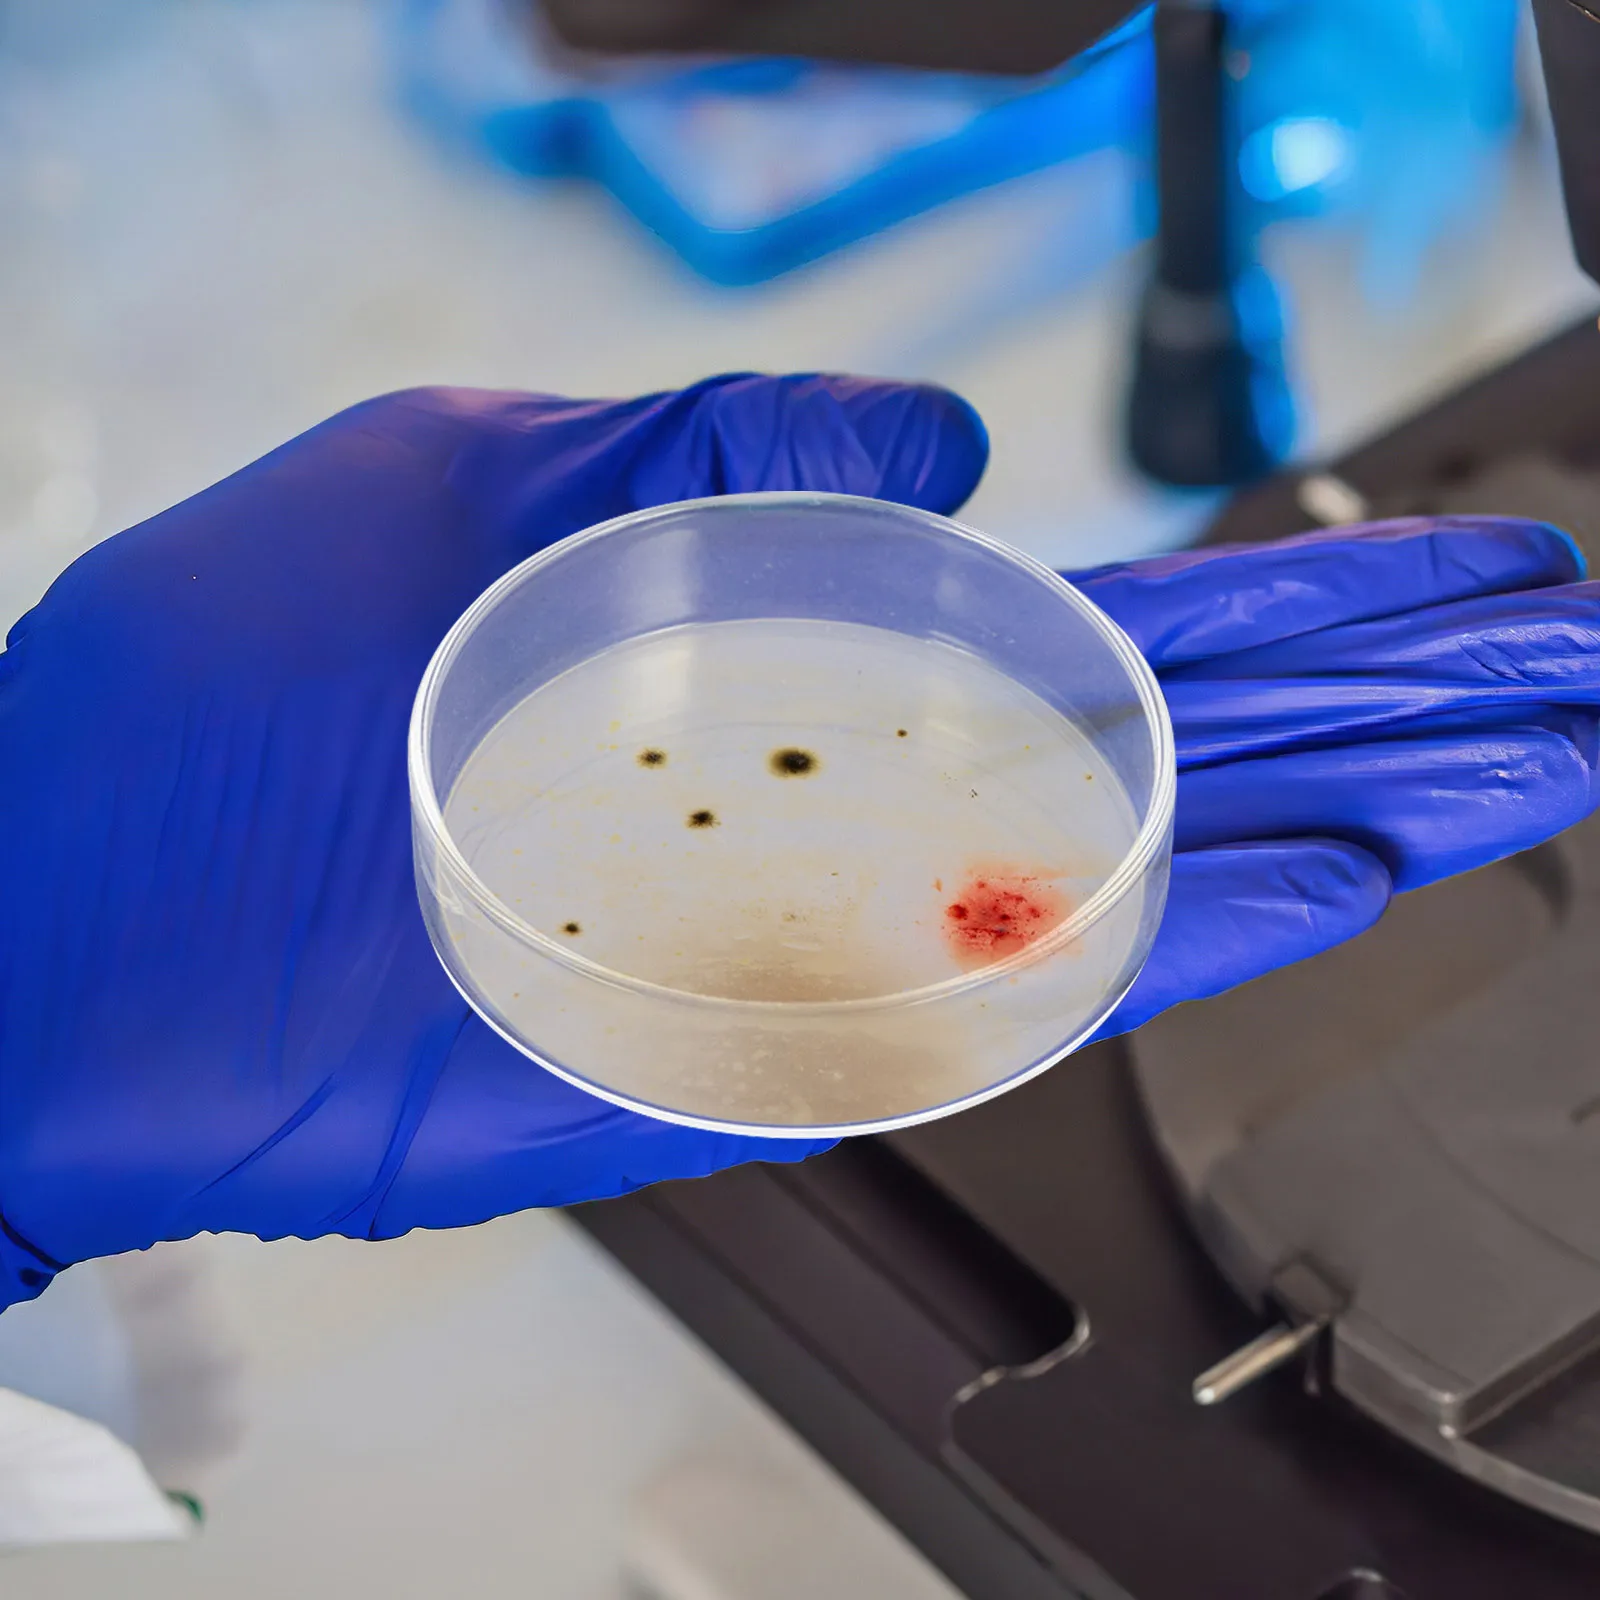
10Pcs 90Mm Reusable Plates Borosilicate Glass Clear View for Agar Preparation Microscopy Observation Laboratory

GCJ188R92A682KA01D
артикул: 1685-GCJ188R92A682KA01D
$0.23
Доставка з: Гонконг
Опис
The Murata Electronics GCJ188R92A682KA01D is a Ceramic Capacitors, low power operational designed for cost-sensitive applications.
Графік зміни ціни & курс обміну валют
Користувачі також переглядали

$107.32
Автошторки TROKOT Standert для Skoda Octavia SCOUT 3 A7 2013- 7 экранов TR073812S, Черный
goods.ru
$7.68
10PCS 4.8W G4 Socket 5050 SMD Mini Led Bulb On DC 12V Replace Halogen Bi-Pin Lamp LED Bulb
aliexpress.com
$2.77
Одиночный треугольный ключ, ключ для утилит, многоцелевой ключ для счетчика воды, практичный,
aliexpress.com
$63.09
JOYTOY Dark Source Warhammer 40K Ultramarines Primaris Technology Warrior Thebestis Brothers 1:18 Кукла для мальчиков коллекционный подарок
aliexpress.com
$38.07
Full car hood dust-proof outdoor indoor UV protection sun protection and scratch resistance For Bentley Bentaga
aliexpress.com
$12.21
Bow Printing Ankle Length Skirt Bodycon Y2k High Waist Korean Style Streetwear Hotsweet Spicy Girls Elegant Gentle Summer Chic
aliexpress.com
$186.00
Установка клапана защиты фильтра SFR400-04, нержавеющая сталь 316, фильтр для орошения и регулятор давления G1/4"
aliexpress.com
$25.14
Car Glow Plug Wiring Harness for Mk4 Mk3 B4 Golf Jetta Beetle Passat 1997-2003 1.9 TDI L4 ALH 028971766
aliexpress.com
$25.42
Small Traveling Box Carrying Box for PS VR 2 Headset Box Organizers Easy to Open Close Hard Carrying Holders Lens Drop Shipping
aliexpress.com
$63.66
Luxury Multicolor Sapphire Ring for Party 10 Pieces 3mm*4mm Natural Sapphire Silver Ring Gift for Woman
aliexpress.com
$10.85
Горячая Распродажа P47M Cat Ear Игровая Bluetooth-гарнитура с разноцветными огнями небесно-голубой
joom.ru![Свободная короткая куртка из хлопка с длинными рукавами, весенняя, новая, однотонная, воротник-стойка, универсальная, повседневная, закрывающая мясо и тонкий верх M [95-55 kg] темно-коричневого
Свободная короткая куртка из хлопка с длинными рукавами, весенняя, новая, однотонная, воротник-стойка, универсальная, повседневная, закрывающая мясо и тонкий верх M [95-55 kg] темно-коричневого](http://img.joomcdn.net/51b0f0cc59ffcf38f15fc84c9d69931ff360827e_original.jpeg)
$52.09
Свободная короткая куртка из хлопка с длинными рукавами, весенняя, новая, однотонная, воротник-стойка, универсальная, повседневная, закрывающая мясо и тонкий верх M [95-55 kg] темно-коричневого
joom.com
$16.83
Женские повседневные брюки с высокой талией, однотонные флисовые термолеггинсы, зимние длинные флисовые брюки для бега из плюша L чёрный
joom.ru
$5.64
Frame Photo Picture Wall Frames 4X6 Display Paper Collage Hanging Tabletop Cardboard Decor Wallet Clipsornament Size Kraft
aliexpress.com
$4.17
Cat Harness Leash Set for Chihuahua Accessories Dog Cat Vest Pug Leashes Walking Tools Walk Out Lead Product
aliexpress.com
$106.79
Кухонный инструмент Pop Frog Половник Силиконовый кухонный кухонный кухонный силиконовый кухонный инструмент Кондитерская кухонная кухонная утварь Силиконовый термостойкий чёрный
joom.ru
$1.43
1 Sheet Night Light Keyboard Sticker Glowing Backlight for Dark Use French English Bilingual Universal Fit Laptop Desktop
aliexpress.com
$9.20
Gay-Lesbian-LGBT-R-RainbowsS Phone Case For iPhone17,16,15,14,13,12,11 Plus,Pro Max Magnetic For Magsafe Wireless Charging
aliexpress.com
$7.82
10Pcs Phone Pendant Stylus Mini Pen for All Capacitive Screens Smooth Writing Experience Glitter Diamond Universal
aliexpress.com
$312.18
back filter integrated oxygen fish tank double pump living room desktop stream tank ultra-white glass fish tank
aliexpress.com
$38.72
Premium Replacement Battery 14.4V 12800mAh for IRobot Roomba Series 600 700 800 900 Robot Sweeper
aliexpress.com
$2,158.06
First layer cowhide sofa glutinous rice cake modern minimalist high backrest small apartment living room straight row leather
aliexpress.com
$19.21
6Pcs Clear Stationery Storage Box Multi-Functional Desktop Organizer for Office School Home Sundries Container Acrylic Pen
aliexpress.com
$36.08
10Pcs 90Mm Reusable Plates Borosilicate Glass Clear View for Agar Preparation Microscopy Observation Laboratory
aliexpress.com
$10.58
Summer Candy Jelly Color Solid Nail Polish Gel 9 Colors Nail Gel-Strong Setting Gel Transparent Jelly Gel Varnishes for Manicure
aliexpress.com





![Сборник сонат [1] New edition
Сборник сонат [1] New edition](http://img.joomcdn.net/ec6d331320ff8163caec4a090e9b82e1587e6042_original.jpeg)



